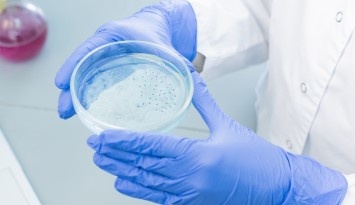

細胞培養
細胞培養は、分子生物学や細胞生物学で用いられる主要な技術であり、細胞の増殖、機能解析、分化、シグナル伝達などの仕組みを研究する上で重要です。また、抗体医薬品やワクチンなどのバイオ医薬品や再生医療(細胞治療)に用いる細胞製剤の製造にも使用されています。
当社では、細胞培養実験に必要な培地、血清・添加剤、細胞分散液、細胞保存液、足場材、培養容器/器材など、一連の細胞培養に使用する製品を取り扱っています。培養細胞や使用用途に合わせてお選びください。
細胞培養の基礎やお悩みを解決するカタログ- 細胞実験する方は必見
細胞培養実験のプロトコルや製品・サービスを掲載したカタログPDFを無料でダウンロードできます。
実験の基礎知識についてもわかりやすく解説しています。細胞培養をしている方、これから細胞を扱う方におすすめの内容です。
細胞培養実験プロトコル

こんな方におすすめ
「細胞培養の基礎知識を身に着けたい」
「培養の各工程の実験プロトコルを知りたい」
「コンタミネーションを防ぐ方法、対処法が知りたい」
「滅菌、無菌操作について学びたい」
無料PDFダウンロードはこちら
製品カテゴリ別 培養試薬カタログシリーズ

こんな方におすすめ
「最適な試薬がなかなか見つからない...」
「複数社のカタログやWebサイトを閲覧するのは非効率...」
「価格や製品情報を一目で比較検討したい!」
各カタログの無料PDFダウンロードはこちら
学術コンテンツ
細胞培養製品
研究分野別の細胞培養用試薬
汎用の細胞培養用試薬
細胞培養とは?

細胞培養とは、動物や植物などの生体組織から分離した細胞を試験管内(in vitro)で増殖・維持することです。生体外で培養している細胞を、培養細胞といいます。生体と比較して、より単純な系として細胞を取り扱うことでさまざまな環境変化に対する細胞の応答を解析できます。
細胞は、生体組織から直接採取し、培養前に酵素などにより分離(初代培養細胞)、あるいはすでに樹立されている細胞株や細胞種を用いる場合があります。
初代培養細胞
初代培養細胞とは、動物や植物の組織から直接採取された細胞を培養したものです。単一の細胞タイプだけでなく、複数の細胞タイプが含まれており、複雑な細胞間相互作用の研究が可能です。
例:肝臓の初代培養細胞には肝細胞、肝単核細胞、クッパー細胞などが含まれています。
細胞株
細胞株とは、初代培養細胞を継代して増殖させた細胞です。生体での構造や機能を失った細胞であり、特定の性質(遺伝子型、表現型など)を維持したまま、安定的に増殖できる状態になります。正常細胞と比較して、増殖速度が速く、コロニー形成率も高くなり、自律性に富んでいます。また、培養中に悪性化することあり、がん細胞に共通する特徴を示すようになります。その結果、培養が極めて容易になり、実験においても非常に使いやすくなります。
例:CHO細胞、HEK293細胞、がん細胞など
細胞種
細胞種とは、細胞株よりもさらに均一な細胞集団を指します。より特異的な性質や機能を有します。
例:特定の薬物耐性を示す細胞など
培養条件:細胞培養で重要な要素とは?

細胞培養において、培養条件は細胞の生存と増殖に不可欠です。細胞の種類によって培養条件は異なりますが、主な要素としては、下記が挙げられます。
- 培地
- 培養容器/器材
- pH
- 温度
- 気体(二酸化炭素、酸素)
- その他の物理的要素(浸透圧、光、滅菌された環境)
培地
アミノ酸、炭水化物、ミネラル、ビタミン、成長因子など、細胞増殖に必要な栄養素を供給します。
培地の選定は、培養細胞の種類や目的に合わせて適切に行う必要があります。生物種・目的別にまとめた培地を下記にご紹介します。
【汎用タイプの基礎培地】
【哺乳類細胞用】
【昆虫細胞用】
【幹細胞・免疫細胞用培地】
【動物胚の研究用】
【特定機能用途】
また、細胞の多くは足場材が必要であり、個体または半固体の基質に接着した状態でなければ増殖できません。
ただし、一部浮遊して増殖させることができる細胞もあります。
培養容器/器材
細胞培養容器のサイズや形状は、実験データの再現性に直接的な影響を与えます。コンタミネーションの防止や接着細胞の足場材としての役割など、適切な培養環境を提供する重要な役割を担っています。
当社では、汎用的な培養容器、共培養容器、特殊培養容器を取り扱っています。
pH
多くの細胞はpH 7.2-7.4を好みますが、細胞の種類や培養条件によって、適切なpHは異なります。pHが適切でない場合、コンタミネーションや増殖阻害の原因となるため、適切な範囲に調整することが重要です。
温度
哺乳類細胞は36-37℃、昆虫細胞は27℃など、培養細胞の種類によって最適な温度が異なるため、それぞれの条件に合った温度を設定する必要があります。
気体
主に酸素(O2)と二酸化炭素(CO2)の濃度設定が重要です。一般的な培養では、5-20%の酸素濃度、5-10%の二酸化炭素濃度が用いられます。
その他の物理的要素
浸透圧、光、滅菌された環境なども細胞の増殖、生存に影響を与えます。
温度、湿度、CO2濃度を一定に保つ方法としては、一般的にCO2インキュベーターが用いられます。
CO2インキュベーター
CO2インキュベーターとは、恒温槽内のCO2濃度を一定にコントロールできる機能を持ったインキュベーターのことです。一般的にディッシュなどの開放系で行う培養では、細胞をCO2インキュベーター内に入れる必要があります。これは培地をpH 7.2 - 7.4という生理的な範囲に調整する必要があるためです。
37℃に保温された環境下では、培地に含まれるNaHCO3からCO2が放出されることによりNa2CO3が残存し、pHが上昇してしまいます。これに対して一定圧の下で炭酸ガスを吹き込むことでpHを下げて調整することができます。一方、密栓したフラスコなどの閉鎖系で培養を行う場合は通常の空気下で培養を行えるよう、NaHCO3の濃度が調整された培地を利用します。
細胞の凍結保存

細胞は、長期間培養することによって遺伝的な変異が生じる場合があります。
凍結保存により、継代による細胞損傷や、老化による細胞損失等を防ぐことが可能です。
動物細胞内には多量の水分が含まれており、培養液中の培養細胞をそのまま凍結すると、細胞内外の水分が結晶化することにより、細胞内小器官や細胞膜などの細胞構造が損傷し、細胞融解後に細胞がが生存できない状態になります。そのため、適切な凍結保存方法により、細胞内外の氷晶形成を防止し、細胞組織の物理的な損傷を防ぐことが重要です。
培養細胞の凍結保存方法としては、急速冷却法と緩慢冷却法があります。
急速冷却法は、グリセロールやエチレングリコールといった耐凍剤を含有する凍結保存液に細胞を浸し、液体窒素で素早く凍結する方法です。ヒトES/iPS細胞や胚細胞などの凍結保存法として用いられています。
一方、緩慢冷却法は、凍結保存液(グリセロールやDMSO)を加え、プログラムフリーザーや発泡スチロールなどの容器を用いて徐々に凍結する方法です。動物細胞全般に用いられる方法です。
【凍結保存に必要な試薬・器材】
培養細胞の形状・性質
培養細胞は、形状・性質から大きく分けて、「浮遊細胞」と「接着細胞」の2つに分類されます。
浮遊細胞と接着細胞
培養細胞は組織から分離された後も、その性質を反映します。生体内において血液中を流れていた細胞は浮遊した状態、組織に付着していた細胞は接着した状態で培養されます。これを浮遊培養と接着培養といいます。
浮遊細胞の例:リンパ球、白血球など
接着細胞の例:上皮系細胞(endothelial cell)、線維芽系細胞(fibroblast)、神経芽系細胞(neuronal cell)など

浮遊培養
血液細胞、特にリンパ球由来細胞は通常の培養条件でも培養器材に付着せず、浮遊した状態で増殖します。浮遊培養は通常のディッシュを用いて行うこともできますが、大量の細胞を培養するには培地を攪拌する必要があり、そのための培養器材もさまざまに開発されています。
接着培養
線維芽様細胞や上皮様細胞の多くは培養系でも何らかの基質に付着しようとし、また付着しなければ増殖できません。例外としてがん細胞や長期間培養された正常細胞の中にも浮遊状態で増殖するものがあります。培養系に移すと培養器材に接着し、単層となって伸展・増殖します。
細胞の初代培養と継代培養
初代培養
初代培養とは、生体組織から細胞を採取し、分散後、最初に播種して培養することを指します。
継代培養
継代培養とは、培養細胞を剥離・分散後、新たな培養容器へと移し替えて増殖、維持することを指します。接着細胞の多くは、継代の際に細胞分散/剥離試薬を用いて細胞ー細胞間や細胞ー器材間の接着を解離させる必要があります。
継代のタイミング
細胞は右図のような増殖曲線を描いて増殖します。停滞期や対数増殖期初期は細胞数も少なく、継代に適しません。定常期以降の状態は細胞の種類や培養条件によって異なります。恒常的な状態を維持するためには対数増殖期後期に細胞を継代する必要があります。

停滞期(lag phase)
細胞が培養環境に適応する時期です。細胞数の増加がほとんど見られません。
対数増殖期(logarithmic phase)
細胞が最も盛んに分裂する時期です。細胞数が指数関数的(2倍、4倍、8倍)に増加します。実験に用いるのに適した状態です。
定常期(stationary phase)
老廃物の蓄積や栄養の枯渇により、細胞の増殖がほぼ停止する時期です。
死滅期(death phase)
細胞が死滅し始める時期で、生細胞が減少します。
細胞の増殖速度は倍加時間(Doubling time, DT)で表します。倍加時間は以下の式で求めることができます。
DT=(t-t0)log2/(logN-logN0) (上図参照)
細胞培養でのコンタミネーションの原因・対策

コンタミネーションとは、培養において本来培養しようとしている細胞以外の生物因子が混入することです。
コンタミネーションの原因としては、主に以下の3つに分けられます。
- 微生物によるコンタミネーション
- マイコプラズマ、ウイルスによるコンタミネーション
- 他の哺乳類細胞によるコンタミネーション
コンタミネーションを防ぐためには、
- 実験操作は一定の手順を決めて行う
- 汚染源となるものをクリーンルームに持ち込まない
ことが重要です。
実験操作は一定の手順で行うことで、汚染の原因を特定しやすく、適切な対処が可能です。
また、汚染源となるもの(ノートやペンなど)をクリーンルームに持ち込まず、清潔な状態を維持することが大切です。
参考文献
- 井出利憲, 田原栄俊 著:「無敵のバイオテクニカルシリーズ 改訂 細胞培養入門ノート」 (羊土社) (2010).
- 黒木登志夫, 許南浩 編:「実験医学別冊 培養細胞実験ハンドブック」 (羊土社) (2004).
- 許南浩 編:「細胞培養なるほどQ&A」 (羊土社) (2003).
- 中村幸夫:「目的別で選べる細胞培養プロトコール」(羊土社)(2012)
- 柿木 章伸:「細胞培養」(Equilibrium Research)(2008)
- 小山秀機 編:「細胞培養ラボマニュアル」(シュプリンガー・フェアラーク東京株式会社)(1999).
- 社団法人生化学会 編:「細胞培養技術」(株式会社東京化学同人)(1990)
製品ラインアップ
-
基礎培地/平衡塩
-
血清/添加剤
-
-
細胞分散/剥離試薬
-
細胞保存液
-
足場材
-
-
- マトリクソーム perLAM (パールカン結合型ラミニンE8断片) シリーズ
- コロニー形成アッセイ用メチルセルロース溶液
- 高研 コラーゲン「AteloCell®」
- キミカ 低エンドトキシン アルギン酸ナトリウム
- クラレ〈スキャポバ®〉PVAマイクロキャリア
- R&D Systems Xenograft / Tumorgraft 用 基底膜マトリックス
- Xylyx社 TissueSpec™ dECM Coating Kit (2D)
- R&D Systems 基底膜マトリックス
- JNC ポリリジン(ε-Poly-L-Lysine)
- EHS ゲル基底膜マトリックス
- 新田ゼラチン Gelatin LET-NP250
- Cultrex UltiMatrix Reduced Growth Factor (RGF) Basement Membrane Extract (BME)
- 新田ゼラチン ゼラチン・コラーゲン試薬
- 新田ゼラチン Cellmatrix® (セルマトリックス) シリーズ
- ポリ-L-オルニチン溶液 (0.1 mg/mL)
- ラミニン溶液
- ビトロネクチン(20-398aa), ヒト, 組換え体, 溶液
- 多木化学 セルキャンパス
- ニッピ コラーゲン試薬
-
-
培養器材
-
-
- 住友ベークライト ELISAプレート
- AGCテクノグラス ピペット
- AGCテクノグラス ガラスベースディッシュ・プレート
- AGCテクノグラス ECMコート製品
- AGCテクノグラス 細胞培養用マイクロプレート
- AGCテクノグラス フラスコ
- AGCテクノグラス ディッシュ
- AGCテクノグラス 遠沈管
- 住友ベークライト 細胞培養用ディッシュ (シャーレ)
- 住友ベークライト ディスポーザブルピペット
- 住友ベークライト 細胞培養用フラスコ
- 住友ベークライト 細胞培養用マルチプレート
- 住友ベークライト スミロンコンパニオンプレート (セルカルチャーインサート用)
- 住友ベークライト 遠沈管
- 住友ベークライト プロテオセーブ®
- 住友ベークライト ステムフル®
- 住友ベークライト セラムチューブ
- PESメンブレン カプセルカートリッジフィルター(CCSタイプ)
-
-
スフェロイド培養試薬/器材











